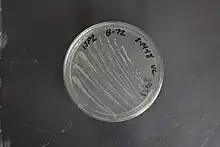

Gluconobacter
Gluconobacter
Taxonavigation
| Taxonavigation: Rhodospirillales |
|---|
|
Prokaryota |
Familia: Acetobacteraceae
Genus: Gluconobacter
Species: Gluconobacter oxydans –
Gluconobacter cerinus –
Gluconobacter frateurii –
Gluconobacter thailandicus –
Gluconobacter sp. NBRC 3243 –
Gluconobacter krungthepensis –
Gluconobacter albidus –
Gluconobacter japonicus –
Gluconobacter sp. AN1-1 –
Gluconobacter sp. B10 –
Gluconobacter sp. EW707 –
Gluconobacter sp. S66-7 –
Gluconobacter sp. MUU7 –
Gluconobacter sp. MUU8 –
Gluconobacter sp. TM-2008 –
Gluconobacter sphaericus –
Gluconobacter sp. RB88-1 –
Gluconobacter roseus –
Gluconobacter sp. H24 –
Gluconobacter sp. NBRC 103581 –
Gluconobacter sp. NBRC 103582 –
References
- Gluconobacter – Taxon details on National Center for Biotechnology Information (NCBI).
This article is issued from Wikimedia. The text is licensed under Creative Commons - Attribution - Sharealike. Additional terms may apply for the media files.